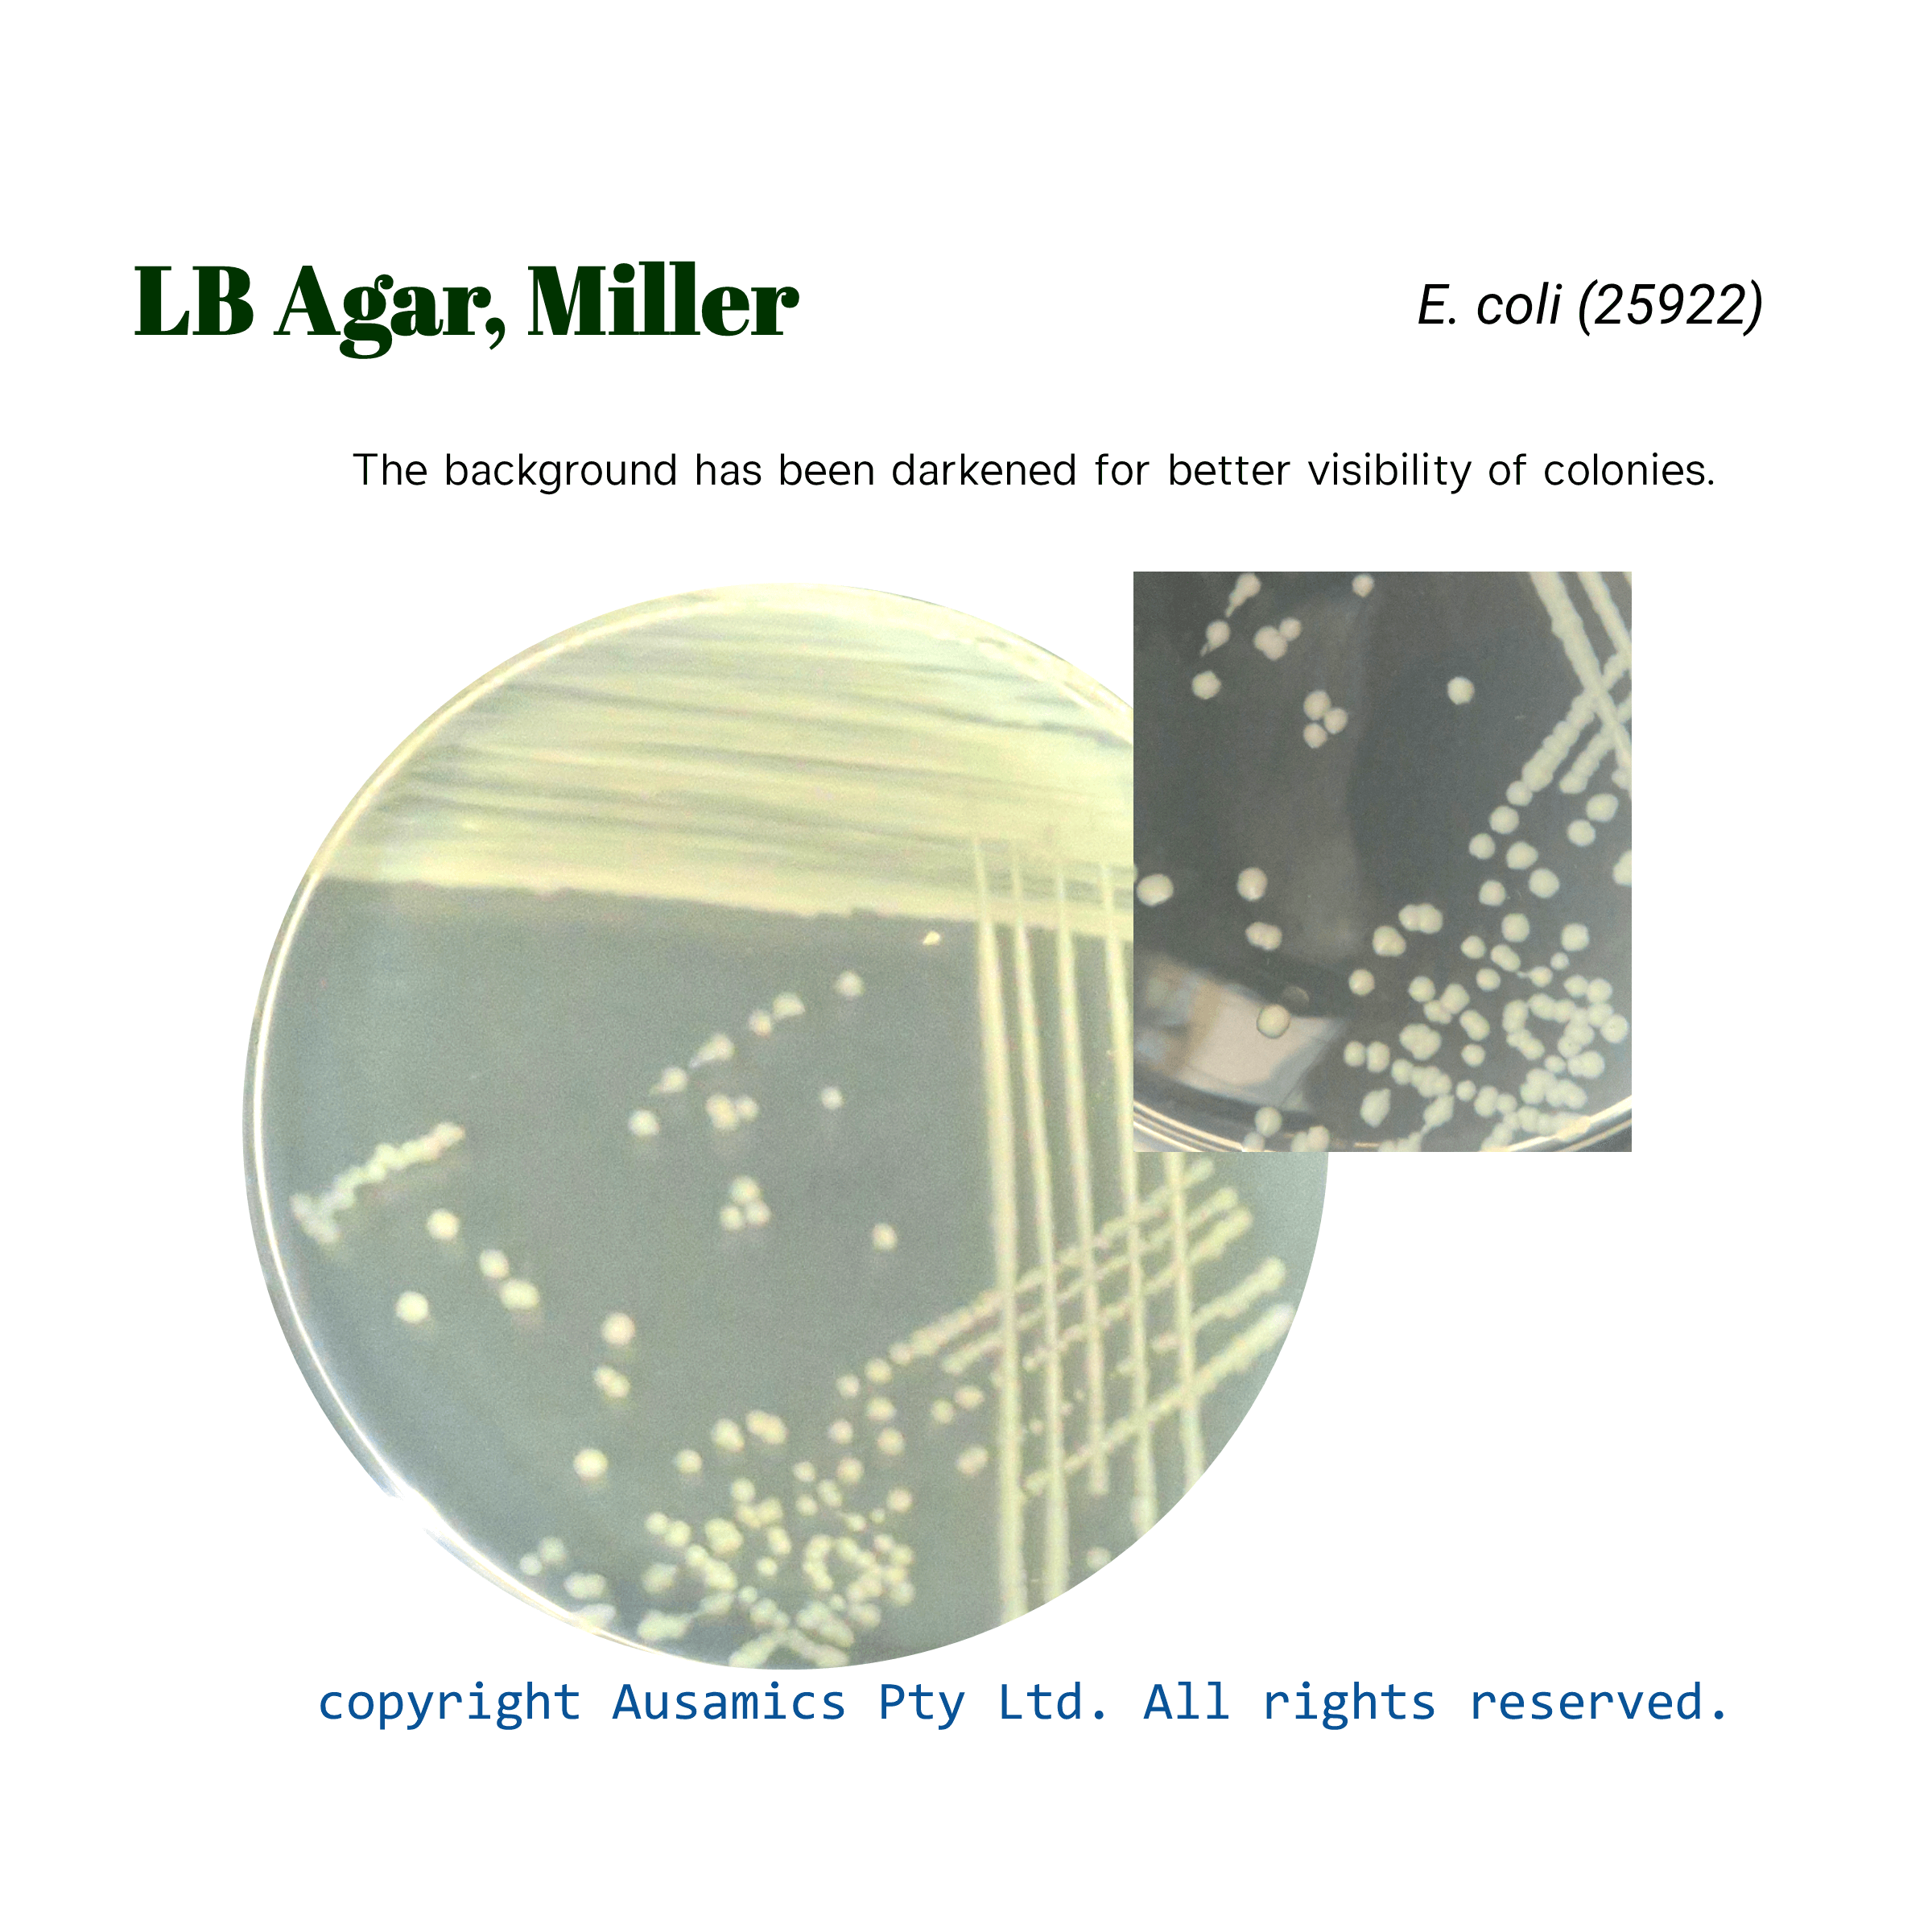
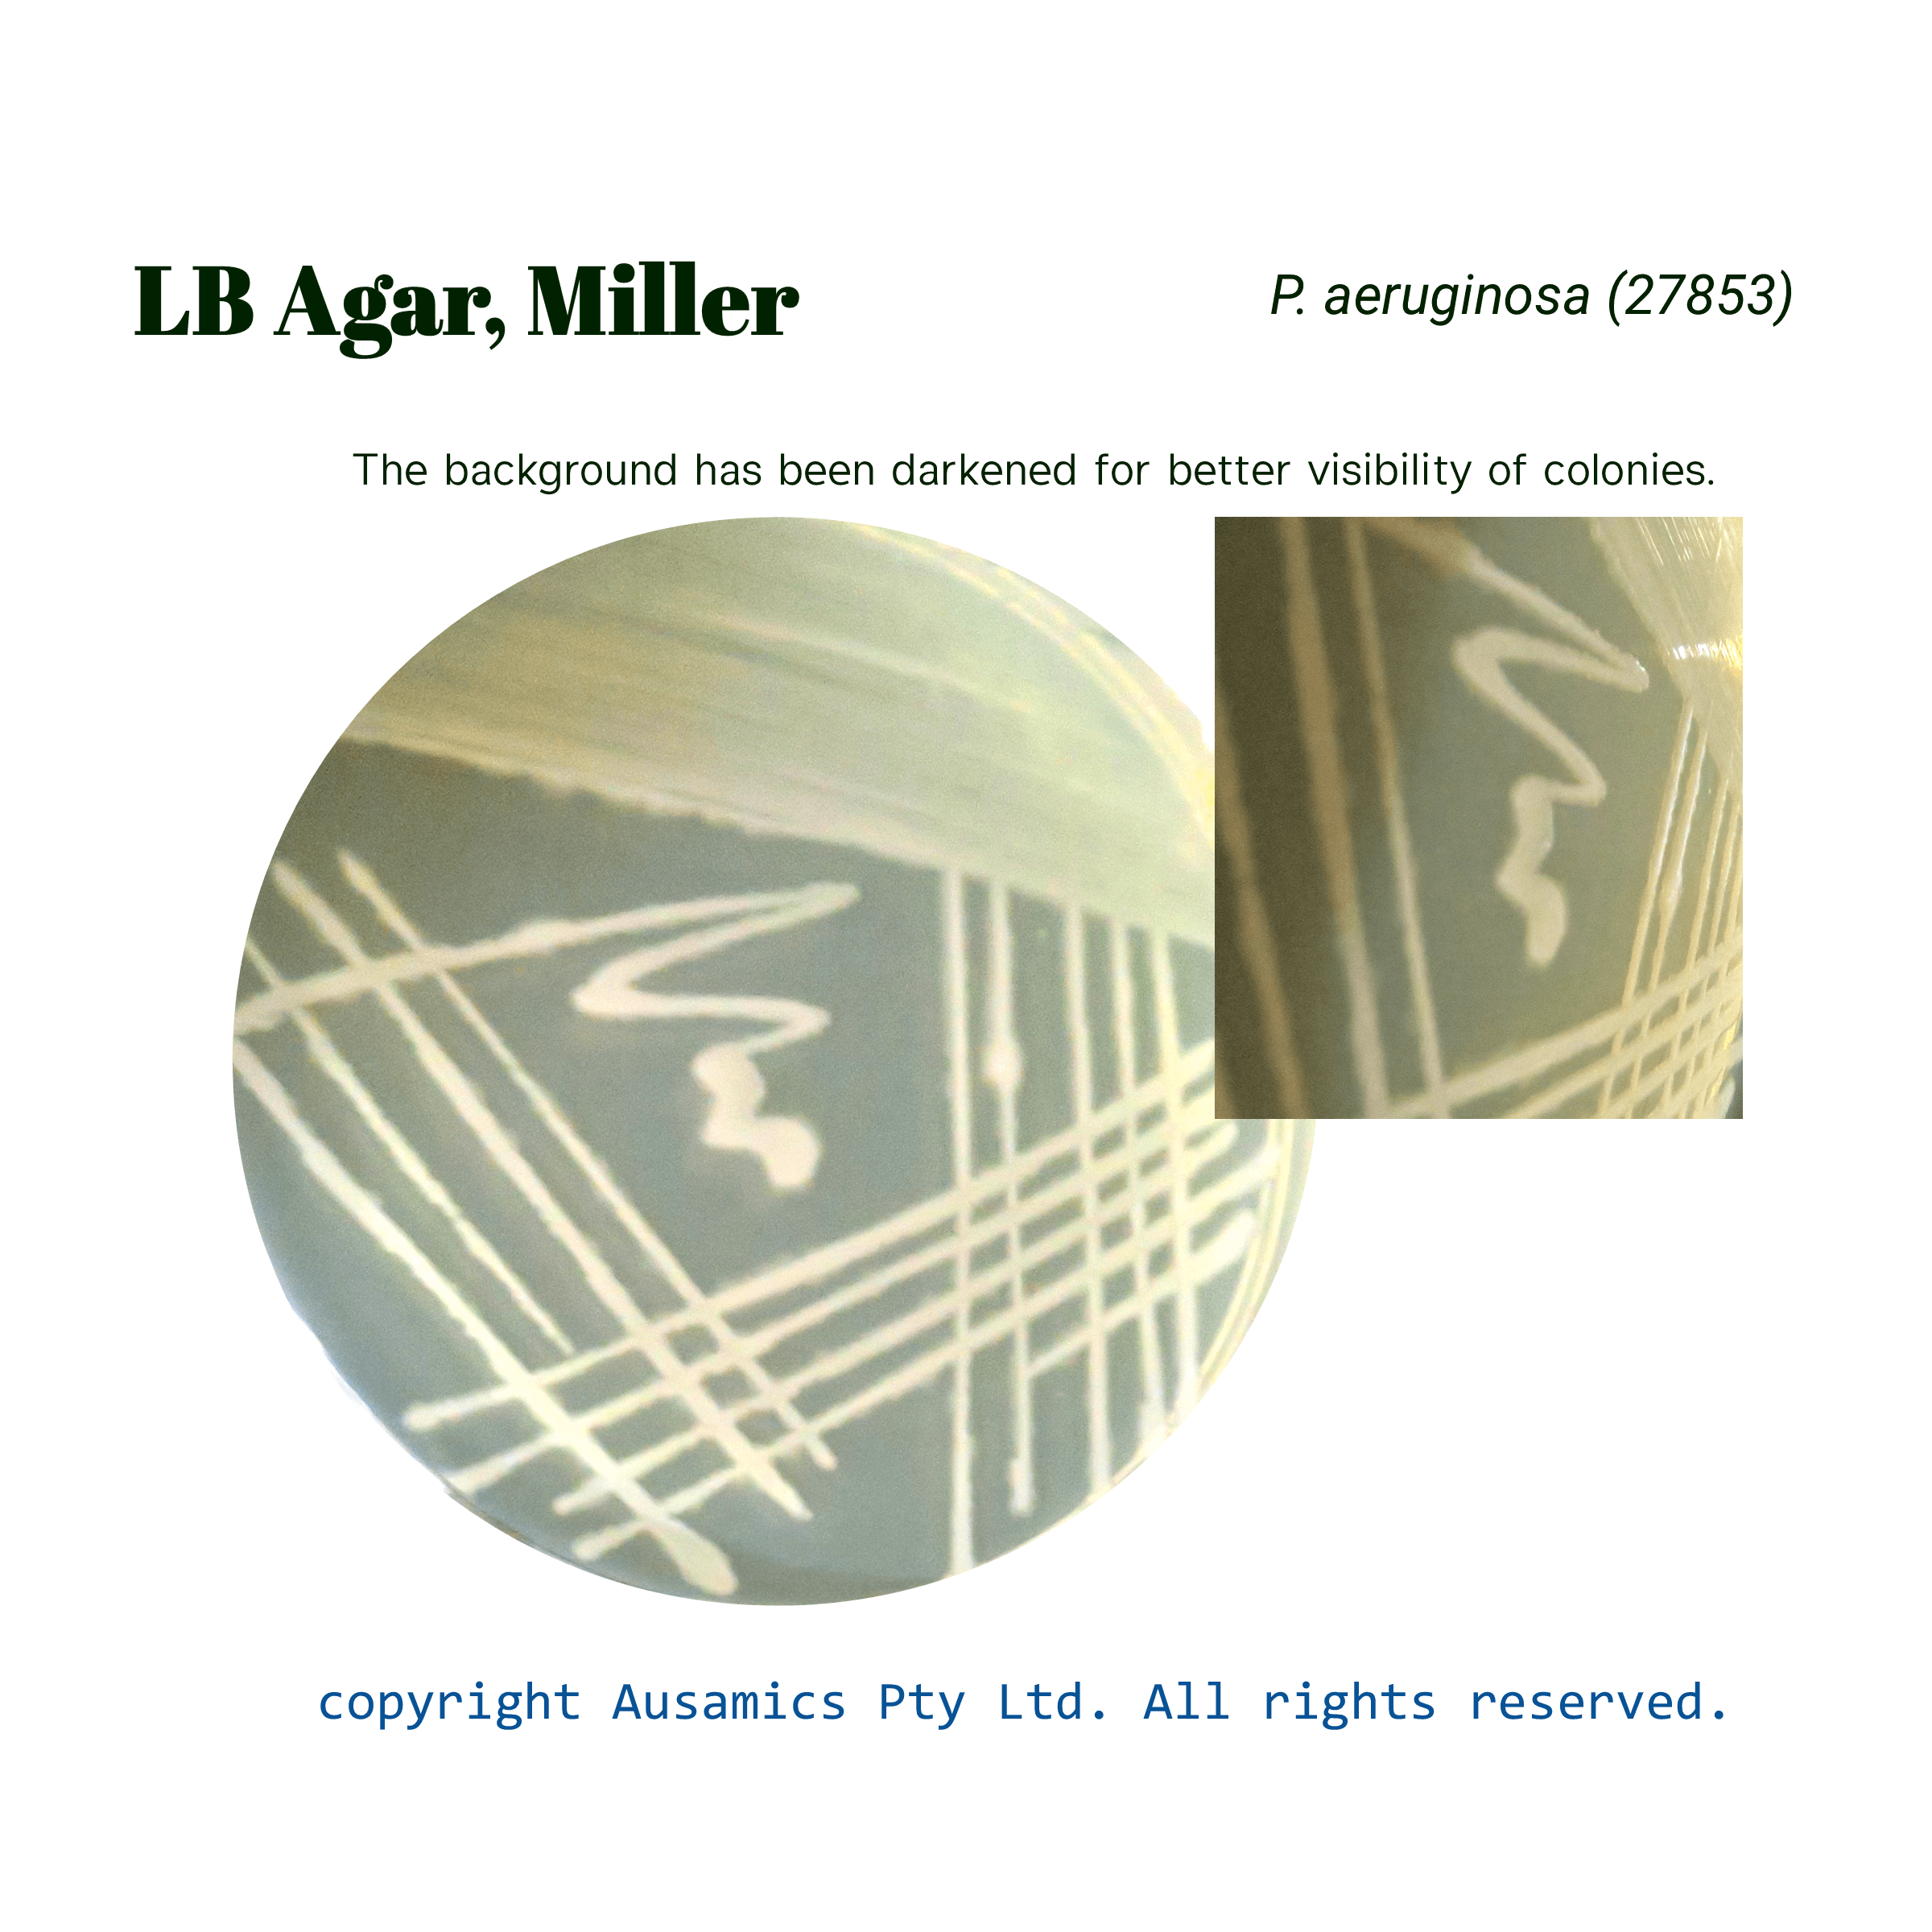

LB Agar, Miller
For the cultivation of E. coli in fermentation and molecular genetic studies.
Category Microbial Culture Media
Catalog Number: AS-1267
- Description
- Composition
- Quality Control
- Microbial Test Results
LB Agar, based on Miller’s LB Medium, is intended to promote the growth of E. Coli strains, especially those that have uses in molecular microbiology. These strains, frequently E. coli K12, have undergone additional mutations to become auxotrophic strains, which are unable to grow on media with little nutrition and are incapable of producing vitamin B. in LB Agar, Vital nitrogen, amino acids, minerals, and vitamins are provided by tryptone, and the B-group vitamins are provided by yeast extract. Osmotic equilibrium is ensured by sodium chloride. Also, Agar is solidifying agent in medium.
Storage
Keep the container at 15-30 °C and prepared medium at 2-8 °C.
Composition| gr/L |
|
| Tryptone | 10 |
| Yeast Extract | 5 |
| Sodium Chloride | 10 |
| Agar | 15 |
| Final pH at 25°C | 7.0 ± 0.2 |
| Dehydrated Appearance | Tan, free-flowing, homogeneous |
| Prepared Appearance | Light amber, very slightly to slightly opalescent |
| Reaction of 4.0% Solution at 25°C | pH 7.0 ± 0.2 |
| For 18 to 48 hours, incubate at 35 ± 2°C. | |
| Organism (ATCC) | Recovery |
| Escherichia coli (25922) | Good |
| Enterococcus faecalis (19433) | Good |
| Pseudomonas aeruginosa (27853) | Good |